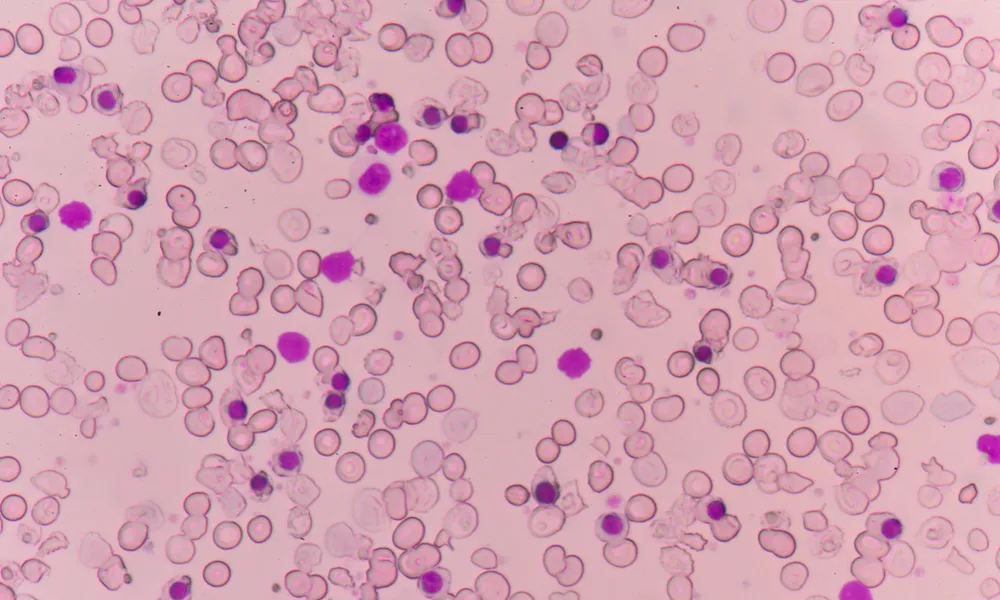
Header Image

The Cyprus Institute of Neurology & Genetics (CING) has unveiled BETA-BET: Targeted Base Editing for Beta Thalassemia, a two-year research project to develop a one-off, curative therapy for the most common forms of thalassemia in Cyprus. Led by the Molecular Genetics Thalassaemia Department (MGTD), the programme targets mutations in the β-globin (HBB) gene that cripple red-blood-cell production and leave patients dependent on lifelong transfusions.
According to CING, the project focuses first on the HBBIVSI-110 mutation, the leading cause of β-thalassemia in Cyprus, advancing a personalised gene-therapy approach that could free patients from chronic anaemia and transfusion cycles. The work is funded with a €198,828 budget from the Research & Innovation Foundation (RIF), co-funded by the European Union and the Republic of Cyprus, and runs for 24 months.
BETA-BET builds on a previous RIF-funded programme with partners at George Papanikolaou Hospital and Aristotle University of Thessaloniki in Greece and the University of Freiburg in Germany. That preclinical study showed that base-editing tools can correct the mutation in hematopoietic stem cells, restore healthy red-blood-cell production, and sustain long-term function in mouse models, outperforming older nuclease-based techniques.
The new phase widens the therapeutic lens to patients known as compound heterozygotes, people who carry the HBBIVSI-110 mutation alongside a different HBB mutation. Globally, compound heterozygotes are more than three times as common as those homozygous for HBBIVSI-110, making this step crucial for clinical impact, especially in countries such as Greece and Egypt, where the mutation’s frequency exceeds 19%. Base editing, often described as a molecular “pencil and eraser,” precisely changes a single DNA letter without cutting the double helix, a design that promises greater safety than earlier gene-editing methods.
A second pillar of BETA-BET is the creation of an engineered virus-like particle (eVLP) delivery platform. These eVLPs are being designed to ferry the base-editing machinery directly to blood-forming stem cells. If successful, this approach would lay the groundwork for in-vivo treatment, a future outpatient injection, potentially avoiding today’s complex and costly “remove-edit-return” cell-therapy process.
“The BETA-BET programme is a crucial step toward a potential cure for the majority of people living with thalassemia,” CING said in its announcement. “By expanding the therapy’s reach and pioneering new delivery methods, this research brings a personalised, one-time treatment closer to reality.”
The project officially began on 1 June 2025 under the coordination of Dr Petros Patsali, Associate Scientist at MGTD, working with Dr Carsten W. Lederer (Head of Department), Dr Nikoletta Papaioannou (Postdoctoral Researcher) and Dr Panayiota Papasavva (Hematologist, Clinician-Researcher). The consortium spans Cyprus and Europe, including Dr Soteroula Christou (State Health Services Organisation’s Thalassaemia Clinic, Cyprus), Prof. Dr Toni Cathomen (University Medical Center Freiburg, Germany), Dr Annarita Miccio (Imagine Institute of Genetic Diseases, France) and Dr Maria N. Dimopoulou (Laiko General Hospital, Athens).
CNA